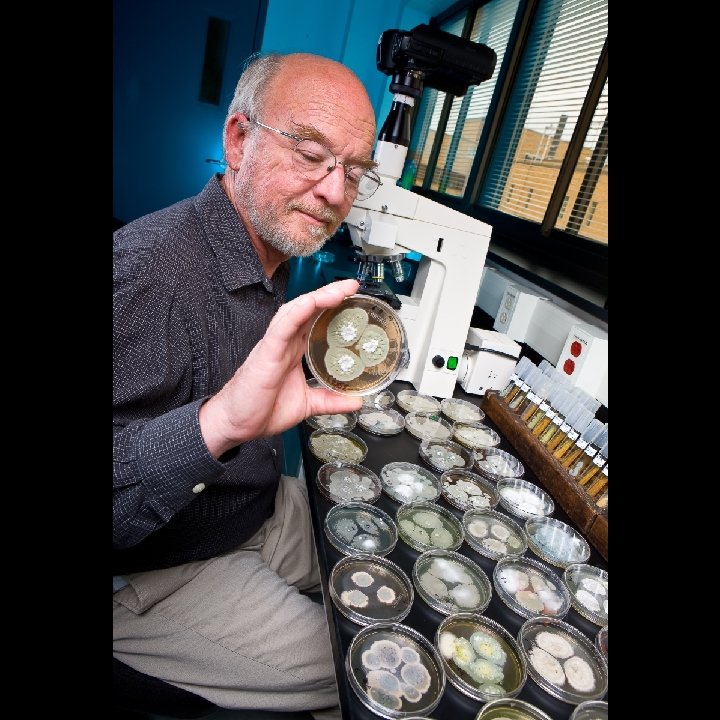

The Agricultural Research Service Culture Collection NRRL Germplasm

- Slides: 19
The Agricultural Research Service Culture Collection (NRRL): Germplasm Accessions and Research Programs Cletus P. Kurtzman ARS Culture Collection (NRRL) Nat’l Center for Agricultural Utilization Research USDA / ARS, Peoria, Illinois USA
ARS Culture Collection (NRRL) Established: 1940 Mission: Collect, maintain and utilize microbial germplasm for agricultural and agro-industrial applications Website: http: //nrrl. ncaur. usda. gov
ARS Culture Collection Accessions General Collections Actinobacteria Bacteria Filamentous fungi Yeasts 9, 000 10, 300 53, 000 15, 000 Patent Collection 6, 000 Annual strain distributions 4, 000
ARS Culture Collection Source of Cultures Thom Collection Aspergillus, Penicillium Harvard Collection of Mucorales N. R. Smith Collection Bacillus Mix Collection Dulmadge Collection Taphrina Bacillus thuringiensis, B. sphaericus J. W. Fell Collection U. S. Army Quartermaster Collection Various NCAUR research programs Other scientists Marine yeasts Biodegradation fungi
ARS Culture Collection Distribution Policies General Collection 12 strains per request / 24 strains per year Required permits must be provided No charge per ARS policy Patent Collection Budapest Treaty Rules
ARS Culture Collection Preservation Lyophilization Ampoules Liquid nitrogen storage
ARS Culture Collection Staff Curators/Scientists (Curatorial duties, ca. 20%) Clete Kurtzman Yeasts Dave Labeda Actinobacteria Kerry O’Donnell Fusarium, Mucorales, etc. Steve Peterson Aspergillus, Penicillium, etc. Alex Rooney Bacteria Todd Ward Listeria Jim Swezey Patent Collection Technical Staff = 7 (Collection duties, 10 -50%)
ARS Culture Collection Scientific Contributions Production strains for: Penicillin Xanthan gum Dextran blood extender Riboflavin Beta–carotene First yeast to ferment pentoses (biomass) Diagnostic gene sequences bacteria, molds, yeasts – food safety, microbial forensics
Challenges for Culture Collections Cost recovery for strain distributions Cost for long-term maintenance Funding for qualified staff Funding/Staff to characterize poorly identified germplasm and for strain verification Back-up sites for cultures and strain data
Germplasm at Risk Abandoned Collections Who will decide their value? Who will take them? Research Materials – Published strains Key strains should be deposited in culture collections and distributed without restrictions Will journals enforce this concept? Research Materials – Unpublished strains – access?
Intellectual Property Patent Cultures Budapest Treaty National Patent Offices Non-Patent Cultures Published cultures – MTAs? Non-published cultures – MTAs? “Rio Treaty” Cultures
Questions ? ? ? No single collection can maintain all microorganisms – can a network of interactive collections be developed? How can long-term funding be developed to ensure the survival and use of established collections?